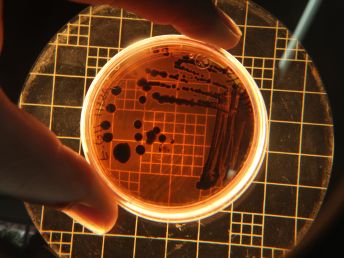
1
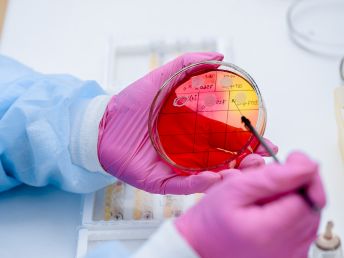
3

Microbiology Services
At BIO-LEO Analytical Labs India Pvt. Ltd., our Microbiology Services ensure the safety, purity, and quality of pharmaceutical, cosmetic, water, and healthcare products. Equipped with a state-of-the-art microbiology laboratory and trained experts, we deliver accurate and reliable microbial testing solutions that meet national and international regulatory standards.
Our comprehensive Microbiology Services include Microbial Limit Testing (MLT), Sterility Testing, Pathogen Detection, Endotoxin Testing, Water Analysis, Environmental Monitoring, and Antimicrobial Effectiveness Testing. Each test is performed using validated methods to ensure the highest level of accuracy and compliance.

Detection of Multi-Range of Pathogens

Anti-Factor Studies
Bacterial Endotoxin Test (BET)

Disinfectant Efficacy Studies

Bioburden Determination

Assay of Vitamins

Sterility Tests

Preservative Efficacy Tests (PET)

Method Validation and Development

Microbial Monitoring of Air Quality

Microbiology Assay of Antibiotics
Our Process
QC testing, product release testing, or specialized microbial studies
Whether you need routine QC testing, product release testing, or specialized microbial studies, our Microbiology Services support your quality assurance programs and help ensure that your products are safe, stable, and contamination-free.
We offer comprehensive detection of a broad spectrum of pathogens to ensure product safety and regulatory compliance. Our microbiology laboratory identifies harmful bacteria, fungi, and yeast using validated methods designed to meet pharmacopeial standards. This service helps prevent contamination, ensures product purity, and supports robust quality assurance across pharmaceutical, cosmetic, and water testing applications.

